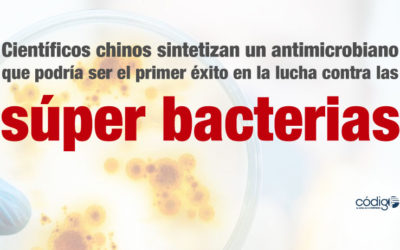
Científicos chinos sintetizan un antimicrobiano producido por una bacteria, que podría ser el primer éxito en la lucha contra las súper bacterias

La nueva planta de producción de vacunas de Sanofi Pasteur en Cuatitlán, dará a nuestro país independencia vacunal en contra de la influenza
Durante la celebración de la Feria Industrial de Hannover Messe (Alemania) 2018, llevada a cabo el pasado mes de abril, Fernando Antunes Sampaio, director de Sanofi Pasteur México, dio a conocer la decisión de ese importante laboratorio para abrir una...
Desarrollan un dispositivo para medir de manera constante y precisa la presión arterial central
Una de las áreas con avances más significativos es la de los dispositivos médicos para la monitorización oportuna de las diversas condiciones y señales corporales, lo que permite a los médicos prevenir y evitar daños físicos mayores, potencialmente...
Investigadores del CIAD desarrollan una microesfera para administrar insulina oralmente
Más allá del reto que representa el diagnóstico temprano de la diabetes mellitus en nuestro país, el monitoreo constante de los niveles de glucosa en sangre, el cumplimiento estricto y real de las recomendaciones médicas por parte de los pacientes, está la...
Investigadores chilenos desarrollan un spray que inhibe la compulsión por el consumo de alcohol
En la cultura popular mexicana existen un sinnúmero de dichos, canciones y películas que hacen referencia al consumo de alcohol y que de alguna manera banalizan e incluso, en algunos casos, justifican una adicción que tiene graves implicaciones y funestas...
Un equipo de científicos consigue inducir por primera vez la regeneración epitelial sin necesidad de injertos
Uno de los problemas más graves y potencialmente mortales para las personas que han sufrido quemaduras en amplias zonas de su cuerpo, úlceras cutáneas extensas y profundas o grandes heridas, es la pérdida masiva y traumática del órgano más extenso que...
Científicos chinos sintetizan un antimicrobiano producido por una bacteria, que podría ser el primer éxito en la lucha contra las súper bacterias
Se ha vuelto recurrente en el ámbito sanitario y científico el hablar con preocupación sobre la franca resistencia que múltiples bacterias presentan ante el arsenal antibiótico existente, lo que cada vez con mayor frecuencia, y creciente ferocidad, pone en...